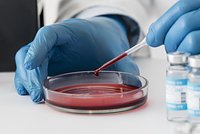

Nature: Человеку пересадили почку с измененной группой крови на универсальную Екатерина Графская (Редактор отдела «Наука и техника»)
Екатерина Графская (Редактор отдела «Наука и техника»)
Фото: sergey kolesnikov / Shutterstock / Fotodom
Международная команда исследователей из Канады и Китая впервые в мире пересадила человеку почку, которой предварительно изменили группу крови с А на универсальную О. Об этом сообщается в Nature.
Чтобы сделать орган совместимым с любым пациентом, ученые использовали специальный фермент, удаляющий антигены типа А с поверхности клеток. После обработки донорская почка фактически превратилась в «универсальный» орган, не вызывающий иммунной атаки у реципиента. Модифицированный орган пересадили 68-летнему мужчине в состоянии смерти мозга в больнице города Чунцин. Почка оставалась функциональной, вырабатывала мочу в течение шести дней и только на второй день начала проявлять первые признаки отторжения.
Материалы по теме: «В один день вся жизнь перевернулась и разбилась вдребезги»12-летнего мальчика спасут дорогие лекарства. Срочно нужна наша помощь23 сентября 2025
«В один день вся жизнь перевернулась и разбилась вдребезги»12-летнего мальчика спасут дорогие лекарства. Срочно нужна наша помощь23 сентября 2025 Первая положительная группа крови:особенности, совместимость при донорстве, питание, характер обладателей крови I+12 августа 2025
Первая положительная группа крови:особенности, совместимость при донорстве, питание, характер обладателей крови I+12 августа 2025
Авторы подчеркивают, что речь идет о первых шагах к новой эпохе трансплантологии. Сейчас органы можно пересаживать только при совпадении групп крови, иначе иммунная система пациента атакует чужеродные ткани. Если технология подтвердит эффективность на живых пациентах, это позволит устранить одно из главных препятствий при пересадках и резко сократить время ожидания донорских органов.
По словам экспертов, следующая цель исследователей — усовершенствовать метод ферментной обработки, чтобы продлить срок работы пересаженных органов и провести клинические испытания на живых пациентах.
Ранее в Китае впервые пересадили человеку легкое от генетически модифицированной свиньи — трансплантат проработал девять дней без признаков немедленного отторжения.
